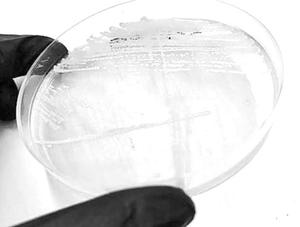

Más leídas
Actualidad | Pág. 4
Firma en la UDI : "Siempre me representó"
Actualidad | Pág. 8
Salud inicia sumario por olores molestos en contra de Cmpc de Nacimiento
Actualidad | Pág. 8
Dos mil 500 alumnos asisten a primer ensayo PSU de la USS
Actualidad | Pág. 8
Vecinos protestan por falta de soluciones para congestión en Boca Sur
Nacional | Pág. 10
Rusia habla de un "fracaso" de la "guerra relámpago" de EE.UU. contra Maduro
Nacional | Pág. 10
Maduro ordena producir alimentos

Nacional | Pág. 9
Detectan en Chile presencia de un hongo resistente a medicamentos
Nacional | Pág. 9
El primer caso detectado en Chile
Deportes | Pág. 15
Argentina, Brasil y Chile ocuparon el podio del Campeonato Sudamericano

Deportes | Pág. 15
Arturo Vidal: "La Champions es el sueño de todos"
Deportes | Pág. 15
Roja Sub 17 va por el título ante Paraguay
Deportes | Pág. 15
Fernández Vial visita a D. Colina

Economía y empresas | Pág. 11
Un 20% de las mujeres de la Región obtiene ingresos inferiores a $288 mil

Economía y empresas | Pág. 11
Cooperativa mapuche mejora la comercialización de papas
Economía y empresas | Pág. 12
"La idea de eliminar el cobro por Cuenta RUT va en contra de la bancarización"

Economía y empresas | Pág. 12
Recicladores reciben esperada certificación gracias a beca
Deportes | Pág. 14
Puerto de Coronel recibe a miles de atletas en tradicional Media Maratón

Deportes | Pág. 14
Daniela Seguel va por el título del W25 de Túnez
Deportes | Pág. 14
Christian Garín disputa hoy la final del ATP de Houston
Deportes | Pág. 14
Paire y Andújar animan final de torneo marroquí
Tendencias | Pág. 16
¿Demanda la formación en innovación nuevos paradigmas?
Tendencias | Pág. 16
Intervención ayudará a escolares a elegir bien lo que comen
Página del lector | Pág. 21
Bloqueo de aceras en Avenida Sanhueza

Espectáculos | Pág. 23
Javiera Mena integra la armada chilena en el festival Coachella

Espectáculos | Pág. 23
"Games of thrones" empieza a protagonizar su conclusión

Espectáculos | Pág. 22
Festival de Teatro del Biobío abre convocatoria de invierno
Espectáculos | Pág. 24
Sello Beast Disco hizo la ruta larga para estar donde está hoy